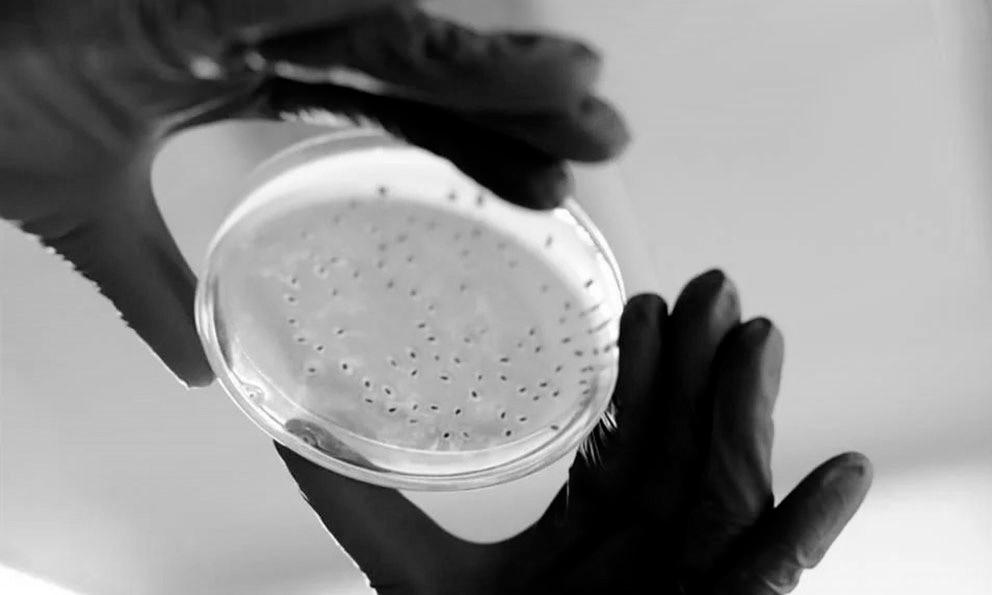

¿Consideras que la vigilancia en el Centro Histórico es suficiente para ir de compras o al Santuario?
![]()









¿Consideras que la vigilancia en el Centro Histórico es suficiente para ir de compras o al Santuario?
INCONGRUENCIA:
al PRI están listos para dejarlo, y siguen hablando del tricolor como si fueran militantes, no terminan de entender que ya son harina de otro costal y esperan que sus ‘declaraciones’ sean tomadas como las de alguien con fuerza política y credibilidad, es el caso de un exdiputado y actual funcionario municipal
PRD CONTRA EL MUNDO:
Sol Azteca recibió su registro como partido político local, no todos los demás partidos lo recibieron de buena gana, tal es el caso del PRI, el Verde y Morena que presentaron las respectivas impugnaciones. ¿En política no hay amigos?

El comisionado Gerardo Navarro dijo que en la transición de Cegaip a otra figura la transparencia debe abonar a favor, sin embargo, no tiene propuestas propias, y confía en lo que decida el gobierno estatal para mantener un programa de transparencia y rendición de
HOY, ÚLTIMO DÍA DE PROSELITISMO:
candidata Lidia Argüello dijo que es su último día para promover su candidatura a la dirigencia estatal del PAN, y consideró que al blanquiazul le urge acercarse a su gente, además de negar que su candidatura esté

Las opiniones expresadas en este documento son de exclusiva responsabilidad del autor y no representan la opinión de Plano Informativo.




A pesar de que están a la vista los estragos, los gobiernos de la ciudad no promovieron medidas que pudieran estimular la economía: Alberto Narváez Arochi
DAVID MEDRANO
PLANO INFORMATIVO
La Avenida Venustiano Carranza, corazón del Centro Histórico de la capital potosina, enfrenta diversas problemáticas que afectan la calidad de vida de habitantes y visitantes. A pesar de los esfuerzos de las autoridades municipales en varios trienios, la realidad es que falta mucho por hacer por esta importante avenida.
Desarrollada a sobreprecio en la administración municipal pasada, actualmente la ciclovía de avenida Carranza se encuentra en la incertidumbre y, mientras tanto, varios de sus componentes han sido destruidos, además este proyecto afectó los negocios de la zona, pues se acabaron los espacios de estacionamiento, y ante la inaccesibilidad, muchos negocios fueron a la quiebra.
A cuatro años de que el Covid-19 impactara a los comercios potosinos, los pequeños y medianos negocios no han logrado recuperarse y continúan enfrentando las secuelas, dijo Alberto Narváez Arochi, representante del Corredor Comercial Cultural Carranza.
Señaló que “La pandemia fue un golpe fuerte para todos y aunque ya pasó lo peor, todavía estamos tratando de recuperarnos. Sin embargo, los problemas se han acumulado; ya no es solo el impacto de las medidas sanitarias, la ciclovía es otro obstáculo para nosotros”.
EL ENTORNO COMERCIAL
La mayoría de los edificios de oficinas ubicados en el Corredor Comercial Cultural
Carranza están abandonados desde hace varios meses, o hasta años, señaló Narváez Arochi, quien dijo que esa es la verdadera estampa de la avenida, la del abandono.
Agregó que en esos edificios se contrajo la actividad, lo que provocó que el entorno sea de escasa o muy reducida actividad comercial; destacó que en el tramo entre las calles de Tomasa Estévez hasta las cercanías del jardín de Tequisquiapan, es donde menos comercios establecidos hay.
El empresario criticó que a pesar de que están a la vista los estragos provocados en edificios de oficinas desde hace varios años, los gobiernos de la ciudad no promovieron medidas que pudieran estimular la economía en esa zona.
Para Francisco Naif Gallegos, presidente de la Asociación Mexicana de Profesionales Inmobiliarios (AMPI), la crisis que sufre la avenida Venustiano Carranza es aún más amplia de lo que se puede ver a simple vista, porque no solo son 60 locales comerciales con la cortina abajo, ya que son 140 las oficinas que permanecen desocupadas.
Reconoció que es crítico lo que registra esta vialidad, que necesita mucho apoyo de los gobiernos para poder ser rescatada y que vuelva a ser atractiva; explicó que el sector de Carranza entre Uresti y el Jardín de Tequis aún tiene potencial, siempre y cuando se generen estrategias que vuel-
EL VANDALISMO, SAQUEO DE FINCAS Y SU ABANDONO HA PROVOCADO UNA MALA IMAGEN DE LA AVENIDA, QUE HA PROVOCADO UNA BAJA DE HASTA 35% EN LA PLUSVALÍA: FRANCISCO NAIF GALLEGOS
van a hacer de este espacio, algo atractivo que fomente la ocupación de locales comerciales y edificios de oficinas.
VANDALISMO, OTRO PROBLEMA
Para el líder de los inmobiliarios potosinos, el vandalismo, saqueo de fincas y su abandono ha provocado una mala imagen de la Avenida Venustiano Carranza, que ha provocado una baja de hasta 35 por ciento en la plusvalía de las propiedades en renta y venta en la zona.
PLANO INFORMATIVO realizó un recorrido por la Avenida Carranza y se pudo confirmar que hay espacios desocupados, locales abandonados y vandalizados, que son la estampa actual de la avenida. En el tramo que va de la calle Uresti hasta Terrazas se contabilizaron 55 edificios en condiciones de abandono. Hay edificios como La Madrid o Viadero, que eran ocupados por elegantes oficinas y hoy están vacíos.
Pero no todo son malas noticias, 2025 podría ser el año en donde la Avenida Carranza pueda recuperar esa plusvalía que tenía, ya que la ciclovía entrará en un proceso de reestructuración, con el que los carriles serán
reubicados a las orillas del camellón central, y se extenderá hasta el Centro Histórico y al parque de Morales, dijo Narváez Arochi. Esa es la propuesta que les ha confirmado el ayuntamiento capitalino, para desarrollar a partir del 2025, conforme al plan diseñado por el Instituto Municipal de Planeación, para generar más de 120 kilómetros de ciclovías. La de la avenida Carranza corresponderá a un cuerpo central de hasta 2 metros, en las orillas del camellón, con su respectiva señalética. Narváez Arochi agregó que ese modelo propuesto es uno que generaría más seguridad a los usuarios de la ciclovía; el proyecto considera que conecte hasta el parque de Morales, y desde ahí, articularse con la avenida Himno Nacional, proseguir esa ruta, y crear una nueva articulación, por la avenida Juárez-Calzada de Guadalupe, hasta el Centro Histórico.
OTRAS SOLUCIONES
Para que la Avenida Carranza pueda recuperar su esplendor hay propuesta que podrían ser importantes; una rehabilitación integral para mejorar la infraestructura, iluminación y accesibilidad, junto con el rescate de fincas en el abandono; patrullaje y seguridad, es fundamental el incremento de la presencia policial; programas de empleo y apoyo a empresarios; y una concienciación ciudadana con campañas de limpieza y cuidado del patrimonio.
La fecha límite para subir al pleno es el 15 de diciembre
JORGE TORRES PLANO INFORMATIVO
La Comisión Segunda de Hacienda y Desarrollo Municipal del Congreso del Estado terminó 27 de las 29 leyes de ingresos para el próximo ejercicio fiscal 2025 de los municipios que le corresponde
revisar, únicamente Zaragoza y San Luis Potosí están pendientes, informó la diputada Dulcelina Sánchez de Lira.
Señaló que la Comisión se reunirá el próximo lunes para avanzar con la revisión de la Ley de Ingresos del municipio de Zaragoza, y en su caso con los valores de uso de suelo y construcción del municipio de la Capital, así como su Ley de Ingresos, aunque se tiene proyectado tener reuniones el martes y miércoles, si es necesario. Agregó que “De hecho tenemos como fecha límite el día 15 de diciembre para estar votado en el Pleno del Congreso los dictámenes, desde luego que entre el lunes y martes, o quizás miércoles tendremos ya dictaminados los dos municipios que faltan”.

Galindo dice que el PRI no le ha notificado su expulsión
A mí no me ocupa, luego hay muchos truquillos, dijo el alcalde
DAFNE LÓPEZ
PLANO INFORMATIVO
Tras haberse informado sobre la expulsión de Enrique Galindo Ceballos del Partido Revolucionario Institucional (PRI), el alcalde capitalino aseguró que aún no le han notificado
“Estoy esperando que me notifiquen, hoy fueron a notificarme pero como no estaba, me dejaron una cita para el lunes, estoy muy nervioso, a ver cómo me va; denme oportunidad de decidir”.

JORGE TORRES
PLANO INFORMATIVO
Lo único que tengo es un llamado medio raro, un video improvisado que hasta la gente se escondía, nadie quería salir en el video”, refirió el alcalde, reiterando que será después de analizar bien “el papelito”, emitirá una postura concluyente.
“Déjenme ver el papelito a ver qué dice, y sobre lo que diga voy a fijar una buena postura porque luego hay muchos truquillos chafas y yo los quiero revisar”.
“O una de dos, o me querían sacar para que no compitamos (...) yo como priista quiero participar; el priismo no es un documento, el priismo se lleva, los priistas de a de veras somos de hueso Colorado; entonces aunque nos expulsen tenemos nuestras convicciones, lo dejo a la reflexión”.
“Qué casualidad que está abierta la convocatoria para la renovación y viene este tema, pero a mí no me ocupa, ya el lunes fijaré una postura muy puntual, déjenme revisar el papelito porque curiosamente no me han querido notificar frente a frente”, expresó.
A pesar de que el Consejo Estatal Electoral y de Participación Ciudadana (Ceepac) aprobó el registro del Partido de la Revolución Democrática (PRD) como partido político local, el diputado Rubén Guajardo Barrera señaló que esta resolución fue impugnada.
Al hacer la revisión en los estrados virtuales del Tribunal
Electoral del Estado, únicamente se localizó un recurso de revisión
TESLP/RR/42/2024, interpuesto por Claudia Elizabeth Gómez López, representante de Morena ante el Pleno del Ceepac, del acuerdo del organismo electoral que aprobó el registro del PRD San Luis Potosí. Pero además de Morena, otros tres partidos presentaron impugnaciones, el Partido Verde Ecologista de México (PVEM), el Partido del Trabajo (PT) y el Partido
Revolucionario Institucional (PRI), estas impugnaciones fueron presentadas directamente ante el Ceepac, de acuerdo con la normativa, y serán notificadas al Tribunal Electoral del Estado. Guajardo Barrera confirmó haber estudiado las impugnaciones promovidas, y a su consideración sí podría revocarse la decisión del Pleno del Ceepac, ya que el organismo electoral pasó por alto algunos criterios que debió tomar en cuenta.

Nuestra postura es no incrementos de manera abusiva, que afecten los bolillos de las y los potosinos, señaló el diputado José Roberto García Castillo, coordinador del grupo parlamentario
de Morena en el Congreso del Estado, quien señaló que la bancada morenista no avalará los Incrementos desmedidos y nuevos impuestos que pretende el Ayuntamiento de San Luis Potosí en su propuesta de Ley de Ingresos 2025.
No solo es en SLP, sino a nivel nacional
ROBERTO GARCÍA
DIPUTADO LOCAL POR MORENA
Destacó que Morena está analizando muy minuciosamente la propuesta del Ayuntamiento de la Capital, pero reiteró que su política no solo es en el Estado de San Luis Potosí sino a nivel nacional, el no votar a favor de cobrar impuestos de manera abusiva.

Al cierre de 2024, la industria automotriz se prepara para cerrar el año en números positivos, con alzas interanuales tanto en producción total, como en las exportaciones y ventas internas.
Durante noviembre del 2024 en México se ensamblaron 351,535 autos ligeros, un nivel que implicó un aumento de 6.7% en comparación con la producción del mismo mes del año pasado.
De acuerdo con el reporte de la Asociación Mexicana de la Industria Automotriz (AMIA), publicadas por el Inegi, siete de las
13 compañías que tienen plantas productoras en el país registraron incrementos en sus niveles de ensamblaje.
Se observó que la japonesa Toyota fue el principal motor de crecimiento de la producción automotriz en México; ensambló un total de 24,838 vehículos ligeros. Este nivel fue casi tres veces mayor en comparación interanual.
Las armadoras que encabezan el ranking de crecimientos más pronunciados fueron la estadounidense General Motors (24.5%), y la surcoreana KIA (10.7%).
La firma que registró la caída más importante en el total de unidades ensambladas fue Mercedes Benz, con una producción 36.7%
menor en noviembre en comparación con el mismo mes del año pasado.
Audi y BMW Group también tuvieron una reducción en sus niveles de producción, con 21.7 y 16.7% menos, respectivamente. En línea con la mayor producción, la industria automotriz registró también un alza en el total de exportaciones de autos ligeros. En noviembre se enviaron al extranjero 289,309 unidades, un 2.8% más que el mismo mes del año pasado.
De enero a noviembre, las exportaciones acumularon un total de 3 millones 213,132 vehículos de pasajeros enviados desde México al extranjero.
Se torna indispensable estar atentos y no confiar en productos a bajo costo
La Secretaría de Seguridad y Protección Ciudadana del Estado alertó sobre estafas en la compra-venta de productos y artículos por internet o redes sociales durante la temporada decembrina, por lo cual el personal
especializado en ciberseguridad estará brindando información, orientación y asesoría a la población que resulte afectada, informó el titular de la Dirección de Tecnologías de la Información, Luis Esteban Macías Jiménez. Con la entrega de aguinaldos hay mayor flujo de dinero, por consiguiente, las personas
acostumbran a usar sus tarjetas para comprar mediante plataformas digitales, compras alusivas a la temporada navideña, como productos, artículos, contratación de servicios, vehículos entre otras cosas, por lo que se torna indispensable estar atentos y no confiar en productos a bajo costo.
Centros Jugueteros esperan repunte de hasta 50% en ventas
Las preferencias de los menores han cambiado en cuestión de juguetes
DAVID MEDRANO
PLANO INFORMATIVO
En la antesala de la Navidad, las primeras dos semanas de diciembre suponen un repunte de venta de juguetes, hasta de un 50 por ciento, señaló Rafael López, empresario del ramo, responsable del
Centro Juguetero en el Centro Histórico.
Con una mayor tradición, dijo que continúa la venta de scooters, patines, patinetas, pelotas o muñecas representativas de series o películas. Sin embargo admitió que otros juguetes tradicionales han perdido predilección entre los menores de edad, cuyas preferencias ahora están en los artículos electrónicos o los teléfonos inteligentes.
Mercados públicos buscan reactivar sus ventas con Expo
Locatarios piden ayuda para superar la crisis que dejó la pandemia
DAVID MEDRANO Y
DAFNE LÓPEZ
PLANO INFORMATIVO
Carlos Franco, presidente de la Unión de Locatarios señaló que este no es el mejor momento para el mercado Hidalgo, uno de los de mayor tradición en el Centro Histórico capitalino, y anunció que para mejorar sus ventas llevarán a cabo del 20 al 24 de diciembre, una Expo Navideña con la que tratarán de amortiguar un poco los impactos negativos que arrastran en este 2024.
Uno de ellos, el principal, la irrupción de las tiendas de productos chinos, a las que calificó de competencia desleal, y que
ha causado la caída en la venta de varios productos ofertados en el mercado Hidalgo.
Nuestros mercados están abandonados Representantes del emblemático Mercado Hidalgo en la capital potosina, piden el apoyo del alcalde capitalino, Enrique Galindo Ceballos, para atender las necesidades de los más de 300 locatarios que se encuentran activos en este espacio comercial, pues manifiestan que, tras la pandemia por Covid-19, no han logrado recuperar las ventas, por el contrario, han disminuido por distintos factores como la presencia de comercios informales, la proliferación de tiendas asiáticas y el incremento de plazas comerciales, reportando hasta un 70% de disminución en la ventas.




Realizaron labores de limpieza, rescate de áreas verdes y rehabilitación del alumbrado público
STAFF
PLANO INFORMATIVO
En la jornada número 62 del programa Cien Días de Gobierno, Cien Días de Talacha, el alcalde Enrique Galindo encabezó una serie de acciones para mejorar la
escuela Francisco Martínez de la Vega, la Avenida Industrias y calles aledañas, en la Colonia Valle Dorado, con el respaldo de vecinos, directores de área y trabajadores municipales. En respuesta a solicitudes de las familias de la zona, las cuadrillas realizaron labores de limpieza, rescate de áreas verdes y rehabilitación del alumbrado público, que beneficiaron especialmente a los alumnos, personal docente, padres y madres de familia de la escuela primaria.
En la Calle Hematita también se realizaron trabajos de limpieza y mejoramiento de los espacios públicos, mientras que personal de la Coordinación de Alumbrado Público trabajó en la reposición de luminarias que presentaban fallas u operaban de manera deficiente. Galindo Ceballos destacó la gran disposición no sólo de los habitantes de esta colonia sino de todas las que se han visitado durante el programa 100 Días de Gobierno, 100 Días de Talacha y las jornadas de Domingos de Pilas.
Servicios Municipales está plantando
Nochebuenas en todos los jardines y áreas verdes
STAFF
PLANO INFORMATIVO
Al llegar la temporada decembrina a San Luis capital, la Dirección de Servicios Municipales lleva a cabo trabajos de rehabilitación en todas las áreas verdes, y en algunos jardines se plantan flores de Nochebuena para embellecer estos espacios públicos con un ambiente navideño.
Uno de los espacios públicos en donde se plantaron flores de

Nochebuena, tradicional y originaria planta de México que florece durante el mes de diciembre,
fue en el Jardín Colón, con lo cual este lugar lucirá con estas visto sas flores.
A partir de hoy, chicos y grandes disfrutarán del Árbol de Navidad, Pista de Hielo, Villa Navideña y eventos culturales.
STAFF
PLANO INFORMATIVO
Con un emotivo mensaje que llama a la unión, la esperanza y la reconciliación en estas fechas decembrinas que inician, el Presidente municipal de Soledad de Graciano Sánchez, encabezó el Encendido Navideño que iluminó completamente la plaza principal, creando un ambiente de alegría e ilusión entre niños, niñas y sus familias que se dieron cita para ser testigos del comienzo de la época más esperada del año.
“Para nosotros, esta es una fecha importante porque nos brinda la oportunidad de estar cerca de
ustedes, y no podríamos dejar de preparar este evento de fin de año; sepan que en próximos días me verán en sus colonias y comunidades, porque vamos a estar llevado las tradicionales Posadas Navideñas, con alegría y entusiasmo”, mencionó el edil, en medio de una colorida explanada que motiva a todos a fotografiarse.
Navarro Muñiz agregó que el apoyo de “nuestro Gobernador, Ricardo Gallardo Cardona, ha sido indispensable para hacer realidad muchos sueños de las y los soledenses, con obras que hoy trascienden en la vida social, y las que próximamente se cristalizarán. El edil deseó a todas y todos los presentes, lo mejor para sus hogares y familias, “es tiempo de paz en nuestros hogares y mi mayor anhelo es que tengamos un año 2025 lleno de salud y éxito en todos los proyectos personales”.

STAFF
PLANO INFORMATIVO
En un ejercicio de diálogo directo entre la ciudadanía y la administración municipal, con el fin de escuchar el sentir ciudadano para la construcción de políticas públicas, inclusivas y accesibles, el Ayuntamiento soledense llevó a cabo un Foro Ciudadano que se desprende de la Consulta Pública para la integración del Plan Municipal de Desarrollo 20242027, jornada que destacó por su amplia participación y el impacto significativo que tendrá en accio
ACÉRCATE CON NOSOTROS
Servicios de arrendamiento:
la población en general. Siguiendo las directrices del Alcalde Juan Manuel Navarro Muñiz, de mantener un gobierno cercano a su gente, se instalaron módulos de atención directa en los que personal de diversas áreas municipales, como Seguridad Pública, Educación, Deportes, Ecología, Desarrollo Urbano, DIF municipal y Desarrollo Social, brindaron información y recibieron sugerencias de la ciudadanía. Alejandro Serrano Cortés, titular de la Secretaría Técnica, subrayó la respuesta positiva de la ciudadanía, quienes durante 15 días participaron de manera activa a través de buzones en distintos puntos del municipio, foros y encuestas tanto físicas como



PLANO INFORMATIVO
La Secretaría de Desarrollo
Urbano, Vivienda y Obras Públicas (Seduvop), entregará en breve el nuevo puente vehicular de Circuito Potosí, a la altura de prolongación Coronel Romero.
La titular de la Seduvop, Isabel Leticia Vargas Tinajero, explicó que los
trabajos incluyeron obras hidráulicas de drenaje pluvial entre calle Marraqueta y Coronel Romero, en su tramo sur, en donde hay un desfogue natural que proviene de la comunidad de Tierra Blanca, garantizando la funcionalidad de carriles laterales.
Dio a conocer que la inauguración será en breve y
que el gobernador Ricardo Gallardo lo entregará a los ciudadanos.
Destacó que el nuevo puente vehicular beneficiará a las y los estudiantes, trabajadores, personas usuarias del Hospital del Niño y la Mujer y vehículos en el tramo sur poniente de la ciudad, en seguimiento al plan estratégico de movilidad.
GOBIERNO DEL ESTADO
No todos los ayuntamientos quisieron participar en esta forma de ahorro
STAFF PLANO INFORMATIVO
La Secretaría de Finanzas (Sefin) realizó un programa especial de reserva económica de enero a septiembre del 2024, para garantizar el cumplimiento de las obligaciones financieras de fin de año, por lo que el lunes 9 de diciembre, 32 municipios recibirán cerca de 220 millones de pesos, que incluyen rendimientos gracias a su ahorro.
La titular de la Sefin, Ariana García Vidal, precisó que este esfuerzo que impulsa el gobernador Ricardo Gallardo Cardona, tiene como principal objetivo respaldar a los municipios en el pago de compromisos laborales, como aguinaldos, prestaciones, y otros gastos inherentes al cierre fiscal del ejercicio 2024, proteger los derechos de las y los trabajadores municipales y asegurar la continuidad de los servicios públicos municipales que brindan apoyo a las y los potosinos. Destacó que en septiembre, previo al cambio de autoridades municipales, la dependencia otorgó recursos ahorrados a 13 autoridades municipales, mientras que
Ofrecerán 12 horas ininterrumpidas de música electrónica y un show audiovisual de primer nivel
STAFF
PLANO INFORMATIVO
Hoy sábado 7 de diciembre, San Luis Potosí será sede del Festival Inverno 2024, un espectáculo que reunirá a DJs internacionales, nacionales y locales en el Ecomuseo del parque Tangamanga I, que ofrecerán 12 horas ininterrumpidas de música electrónica y un show audiovisual de primer nivel.
Como parte de la amplia variedad de espectáculos de sana convivencia para las familias potosinas que promueve el Gobierno del Estado, que encabeza Ricardo Gallardo Cardona, el Festival Inverno 2024 contará con una cartelera diversa que combina lo mejor de la escena internacional con el talento nacional y local.
La titular de los Centros Estatales
de Cultura y Recreación Tangamanga (Cecurt), Ana Rosa Pineda Guel, resaltó que, este tipo de eventos promueven el talento local y fortalecen la identidad del Estado como un destino cultural y turístico de primer nivel, acercando eventos de calidad y más apoyo a las y los potosinos, posicionando a San Luis Potosí en el mapa de los festivales musicales.

otros 13 decidieron no participar en el programa, por lo que no contarán con este recurso.
Los que no recibirán ahorro son Cárdenas, Cerro de San Pedro, Ciudad Fernández, Guadalcázar, Lagunillas, Matehuala, Rayón, Rioverde, Villa de Arriaga, Venado, Villa de la Paz, Santo Domingo y Soledad de Graciano Sánchez, y resaltó que algunos previeron los recursos; sin embargo, otros requerirán de créditos adicionales.
García Vidal dijo que los municipios que recibirán el mayor monto de recursos son San Luis Potosí con 84 millones de pesos, Ciudad Valles con 17, Tamazunchale 11 y Xilitla nueve millones.
STAFF
PLANO INFORMATIVO
El gobernador Ricardo Gallardo Cardona inició las posadas navideñas en el Altiplano, con familias de Charcas, Venado y Moctezuma, donde el mandatario llevó a cabo la entrega de juguetes
para las niñas y niños.
El mandatario expresó que a partir del jueves 5 y hasta el 20 de diciembre, su administración llevará “el espíritu navideño” a todas las regiones de San Luis Potosí, creando “momentos inolvidables” para las familias potosinas y fortaleciendo la sana convivencia.
Además de las diferentes actividades y dinámicas para los más pequeños, como juegos y rifas de regalos, entregó a las y los adultos mayores cobertores para enfrentar la temporada de frío.


DAFNE LÓPEZ PLANO INFORMATIVO
Karla García, de Huella Amiga, indicó que durante la temporada decembrina y Año Nuevo incrementa de manera considerable la venta de lomitos y gatitos, pues suelen formar parte de los obsequios, principalmente a menores de edad.
Por ello exhortó a la ciudadanía a tomar conciencia y no contribuir a la compra/venta de estos animalitos, pues de esta manera se fomenta la práctica de utilizarlos como “máquinas para tener crías”, actividad que algunos de manera irresponsable, aprovechan y lucran en esta temporada decembrina.
La defensora de animales pidió optar por adoptar (responsablemente) a animalitos que necesitan de un hogar; sin embargo, puntualizó que antes de llevar a cabo la adopción, es necesario hacer un análisis de conciencia, para determinar si realmente pueden atender al animalito de por vida.

Antes de adoptar, es necesario un análisis de conciencia para determinar si realmente pueden atender al animalito de por vida
En 2023, las estadísticas de salud mental en México revelaron preocupaciones significativas, pues trastornos como la depresión y la ansiedad afectan al 20 por ciento de la población. La pandemia de COVID-19 exacerbó estos problemas, elevando los niveles de ansiedad, depresión y estrés en la población.
Recientemente, San Luis Potosí fue sede del Congreso Nacional de Salud Mental, donde se presentaron diversas iniciativas para mejorar la salud mental en la región, como campañas de sensibilización y programas de atención comunitaria. Durante el congreso, expertos como Juan Manuel Quijada, comisionado nacional de Salud Mental y Adicciones, abordaron temas cruciales, incluyendo la prevención del suicidio, el impacto de las drogas y la salud mental en adolescentes.
Las autoridades locales y organiza-

ciones no gubernamentales están trabajando para aumentar la visibilidad y el acceso a servicios de salud mental, con el fin de enfrentar los retos actuales en este ámbito.

UASLP y Copocyt reconocen a estudiantes del programa ADA
STAFF
PLANO INFORMATIVO
La Universidad Autónoma de San Luis Potosí (UASLP), en colaboración con el gobierno del Estado, a través del Consejo Potosino de Ciencia y Tecnología (Copocyt), reconoció a 230 estudiantes de nivel medio superior que participaron en el ADA, Programa de fortalecimiento en STEM+ para Mujeres Adolescentes, actividad que tuvo lugar en el Auditorio del Centro de Emprendimiento e Inno-
vación Potosino de la máxima casa de estudios.
En la ceremonia de clausura de la región centro destacó la presencia de alumnas de diversos planteles del Colegio de Bachilleres (Cobach), Centro de Bachillerato Tecnológico Industrial y de Servicios (CBTiS), Colegio de Estudios Científicos y Tecnológicos (CECyTE), Harkness Institute y del Instituto Lomas del Real, así como investigadores y titulares de las instituciones participantes del programa.
Hay tres pacientes covid hospitalizados esta semana
DAFNE LÓPEZ
PLANO INFORMATIVO
Arte sacro manifestado a través de obras pictóricas y escultóricas de orígenes diversos, así como la muestra de un extenso bagaje de escritos y objetos sagrados, forman parte de la colección inaugurada en el Museo del Virreinato, cuyo propósito es reflejar la presencia franciscana en la Nueva España, particularmente en San Luis Potosí, pues la influencia y presencia de la orden, continúa trascendiendo con el pasar de los años.
Durante el evento protocolario, encabezado por la directora del sitio museístico, Elizabeth Rodríguez Romero, se enfatizó en la importancia y esfuerzo de dicha colección, cuya antigüedad de algunos de los objetos exhibidos, realza el nivel de relevancia y de la exposición que estará vigente hasta marzo del año 2025.


DAVID MEDRANO
PLANO INFORMATIVO
Un operativo especial de seguridad será desplegado en los perímetros A, B y C del Centro Histórico, para reforzar la vigilancia e inhibir el delito, durante la temporada navideña y las fiestas tradicionales guadalu-
STAFF
PLANO INFORMATIVO
panas del 12 de diciembre, explicó Amparo Rosillo presidenta de Nuestro Centro AC.
Este dispositivo estará activado desde las 9:00 horas de mañana domingo.
La Calzada de Guadalupe, los corredores comerciales de Hidalgo, Zaragoza, o el gastro-
nómico instalado en Carranza, y las plazas principales, expuso que son las zonas identificadas, en las que se requerirá aumentar la presencia de agentes preventivos, ante el incremento de la afluencia al Centro Histórico, y que comenzó a detectarse desde esta semana.

Con el objetivo de implementar acciones orientadas a la prevención y reducción de la incidencia delictiva en el municipio de San Luis Potosí, se realizó una reunión interinstitucional en las instalaciones del C4 Municipal. En este encuentro participaron el titular de la Secretaría de Seguridad y Protección Ciudadana (SSPC), Comisario Juan Antonio Villa Gutiérrez; el titular de la 12va. Zona Militar de la Defensa, General
STAFF
PLANO INFORMATIVO
Ante la llegada de feligreses a la Basílica de Guadalupe y la visita a los diversos atractivos navideños colocados en calles del Centro Histórico se incrementa presencia de oficiales para garantizar la seguridad peatonal y la movilidad de automovilistas.
Estas acciones, forman parte del operativo “Diciembre Seguro 2024” de la SSPC Capitalina, el cual arrancará el próximo domingo 8 de diciembre en el Jardín Colón.
La Secretaría de Seguridad y Protección Ciudadana (SSPC) a través de la Dirección General de Policía Vial y Movilidad ha activado dispositivos de seguridad vial en los accesos al Centro Histórico y a lo largo de la Calzada de Guadalupe, ante el incremento de visitantes y feligreses que acuden a estos puntos con motivo de
las celebraciones decembrinas. Ante la llegada de caravanas y peregrinaciones a la Basílica de Guadalupe, se ha dispuesto de personal operativo de vialidad a lo largo de la Calzada de Guadalupe y las intersecciones de General Fuero, Gómez Farías, Fernando Rosas, Ontañón, Diez Gutiérrez y Joaquín Riva Palacio, para dar prioridad al paso de peatones y mantener el ordenamiento de vehículos que se desplazan en calles aledañas.
El dispositivo es reforzado con personal de Policía Vial a bordo de motocicletas y patrullas, los cuales realizan recorridos para evitar el estacionamiento en doble fila así como en la canalización del tránsito vehicular a vías alternas en diferentes momentos del día en que las caravanas religiosas se congregan en el santuario guadalupano.

Capacitan a personal para atención de salud mental
STAFF
PLANO INFORMATIVO
Los trastornos mentales, neurológicos y por consumo de sustancias (MNS) son muy frecuentes y representan una gran carga de enfermedad y discapacidad a nivel mundial, Aproximadamente 1 de cada 10 personas sufre un trastorno de salud mental, pero solo 1% del personal de salud a nivel mundial presta servicios de atención de salud mental.
En los Servicios de Salud de San Luis Potosí, se brinda capacitación permanente en la guía Mental
Health Gap Action Programme (mhGAP) al personal de primer y segundo nivel de atención no especializado en salud mental, logrando hasta la fecha contar con 1,937 personas capacitadas en la misma. En las capacitaciones, cada uno de los módulos consta de tres secciones: evaluación, manejo y seguimiento, asimismo, incluye un esquema principal, que proporciona información sobre las formas más comunes de manifestación de los trastornos prioritarios, y desde allí se guía al personal de salud, a los módulos pertinentes.


ME PREGUNTÓ UN ESTIMADO AMIGO, profesional del Derecho, refiriéndose en la charla al cambio que podemos apreciar en los comportamientos sociales una o cuando mucho un par de generaciones atrás en temas como la violencia, el desprecio por lo que sucede a los demás, la inseguridad, la delincuencia organizada, las extorsiones, los secuestros, el abandono de personas, los fraudes, robos, asaltos y la corrupción.
EN FIN, TODAS ESTAS QUE, SI BIEN no son algo nuevo, sí resultan mucho mayores en cantidad, en crueldad, falta de humanismo y en escándalo. Hablamos también de cómo todo esto permea hacia la política, las instituciones, organizaciones y la familia. Se dialoga de la pérdida de valores, de responsabilidad social y de civismo.
ALGUIEN MENCIONÓ CON relación a los comportamientos, al descaro, el cinismo, la falta de vergüenza y la impunidad a la “Teoría de las ventanas rotas”. Como fue un tema apenas sugerido, me interesó revisarlo.
APENAS EL 14 DE OCTUBRE pasado falleció a la edad de 91 años Philiph Zimbardo, estadounidense de ascendencia italiana hijo de migrantes que llegaron a Nueva York. Este estudioso de la Psicología ha dejado un legado para el mundo con sus aportaciones en Psicología Social, y precisamente viene a colación su trabajo porque bien pudiéramos encontrar algunas explicaciones para el tema que hoy nos ocupa, pues sus investigaciones siempre enfocaron los factores del entorno como influencia en los individuos.
VEAMOS, ZIMBARDO CONVOCÓ en 1971 a su equipo de estudiantes de Psicología en la Universidad de Stanford, a llevar a cabo un experimento académico que, aunque tal vez nunca imaginaron, habría de trascender en el tiempo y la ciencia hasta ahora y seguramente por muchas décadas más.
SE TRATABA DE INVESTIGAR, A través de Conejillos de
Indias que previamente reclutaron, el comportamiento de los seres humanos estando encerrados. Para ello se requiere tener una cárcel y reproducir lo más fielmente posible el encierro por varios días, que en este caso sumaron seis.
SE OPTÓ POR UN SITIO MÁS QUE cercano a la Universidad, es decir el propio Campus de esta, donde dispusieron para el evento experimental de instalaciones de la Universidad, lo que vino a darle el nombre a ese primer trabajo exitoso de “Experimento de la Cárcel de Stanford”, pues literalmente la Universidad de ese nombre se convirtió y fue utilizada al menos en una parte, como una Cárcel.
EN EL ESTUDIO SE DESTINÓ A UN buen número de los reclutados a desempeñarse como los reclusos y otra cantidad menor a desempeñar el rol de los custodios.
LOS RESULTADOS Y observaciones del fenómeno resultan múltiples, pero al menos vale la pena enunciar las que vienen más al caso: por ejemplo, se pudo observar que en un buen porcentaje de quienes estuvieron como reos se dieron actitudes depresivas y de desaliento; en otros se percibió ansiedad y en otros más, actitudes violentas y conductas delictivas.
EN OTROS MOMENTOS ALGUNOS reclusos llegaron a alternar los diferentes comportamientos descritos. Entre los 24 reclutados para que desempeñaran los roles de custodios y guardias al azar, empezaron a presentarse problemas y el experimento terminó por cancelarse, lo que habla de la influencia del encierro y el aislamiento, incluso en una cárcel que se sabía era temporal.
CON INDEPENDENCIA DE LA enseñanza que da al traste con muchas tesis de reinserción social, vale aquí considerar que hay muchos tipos de cárceles y que la sociedad misma puede constituir una; al respecto también conviene acudir a la “Teoría de las Etiquetas” como una corriente sociológica que establece cómo las percepciones iniciales sobre las per-
JOSÉ LUIS SOLÍS BARRAGÁN

@josesolisb

LA POLÍTICA PÚBLICA PUEDE SER entendida como el “Gobierno en acción”, es decir los órganos del Estado actúan de forma coordinada movilizando recursos para la consecución de un objetivo planteado.
POLÍTICA PÚBLICA ES UN concepto complejo para nuestro país, dado que parte de una base democrática, es decir para que realmente construyamos políticas, es necesario que la ciudadanía participe como un agente legitimador de la acción y multiplicador de recursos, ello genera corresponsabilidad y por supuesto mecanismos de rendición de cuentas.
DE LA POLÍTICA PÚBLICA SE desciende al concepto de programa gubernamental, que es lo que muchos miembros de la clase política confunden con las políticas; en este eslabón, lo que tenemos son acciones institucionales que contribuyen a la consecución de un objetivo mayor que es la meta de política.
PARTO DE LO ANTERIOR, CON LA finalidad de contextualizar que, si bien las políticas plantean acciones de Gobierno, la realidad es que no deben ser acciones desarticuladas o improvisadas, sino requieren un proceso cognitivo profundo, en el que se considere la pertinencia y congruencia de las acciones para el logro de los objetivos y metas.
CUANDO LOS GOBIERNOS construyen políticas públicas, primero lograr hacer que el uso de los recursos públicos sea mucho más eficiente, pero además garantizan la eficacia de los mismos, toda vez se tiene claridad de a dónde se quiere llegar; como segundo punto, al contar con un proceso deliberativo con características democráticas, es posible enlazar a los elementos centrales del Estado, es decir ciuda-
DESDE LA CIUDAD DE MÉXICO
danía y poder soberano delegado a las instituciones gubernamentales; y por último, es posible definir el fin mismo del Estado, es decir el bien público temporal.
ESTO SOLO ES UNA MUESTRA DE las bondades que nos puede arrojar un gobierno que piensa en políticas públicas y no actúa desde la ocurrencia o contentillo del gobernante, ya que mientras las políticas garantizan la verdadera articulación de los recursos disponibles para llegar a un objetivo construido; la ocurrencia solo nos hace dar pasos sin sentido a donde el gobernante considere pertinente, pero ello no implica que vayamos en un rumbo correcto.
EN MÉXICO MUCHO SE HA hecho por intentar trazar caminos que orienten a que los gobiernos construyan políticas públicas, si bien el ámbito local y municipal la brecha es muy grande, la realidad es que a nivel federal se han generado algunos instrumentos que facilitan acercarnos un poco al concepto, aunque como hemos comentado, en el país se vuelve complejo, dado el componente democrático que requieren y que los gobernantes no comulgan en sí, sino que prefieren continuar en la simulación de los actos y de actores.
SIN EMBARGO, PESE AL AVANCE en materia de políticas públicas es claro que hemos sido testigos de que,en los últimos gobiernos, las decisiones de los gobernantes se han tomado más a partir de la emergencia y la ocurrencia y con ello, se rompe por completo la lógica de la planeación en la toma de decisiones.
EL GOBIERNO DE ENRIQUE PEÑA Nieto si bien en materia de reformas estructurales tenía claridad del rumbo que se quería tomar, en políticas no hubo nada que apor-
sonas pueden llegar a influir de tal manera en las personas, y sobre todo en los jóvenes, explicando la delincuencia juvenil y otros muchos comportamientos.
ESAS ETIQUETAS SE VAN colocando con más facilidad y frecuencia en los entornos carcelarios que pueden constituirse hasta en las presiones sociales consumistas, el descubrimiento de no poder alcanzar los mínimos de desarrollo, que sucede por ejemplo en las nuevas generaciones a las que no les resulta ni resultará factible adquirir sus propias viviendas, pensiones de retiro y en fin, un mínimo crecimiento y realización a pesar incluso de contar con formación profesional.
PERO LA MÁS IMPORTANTE explicación del estado actual de descomposición social lo encuentro en la teoría de “LAS VENTANAS ROTAS” que parte del experimento que Zimbardo y otros colegas realizaron en dos sitios diferentes de Estados Unidos colocando dos automóviles de igual y regular modelo y rango en las calles del Bronx en Nueva York uno, y el otro en un barrio que era reconocido entonces por su tranquilidad, riqueza de sus habitantes y lujo en Paloalto, California.
EL DEL BRONX, RECONOCIDO ESTE lugar como sitio de criminalidad fue desvalijado, destrozado y robadas todas sus partes; pintarrajeado y vandalizado en tan solo media hora.
EL DEL BARRIO DE CALIFORNIA estuvo sin ser tocado durante casi un mes y entonces vino el experimento: durante una noche se le rompió un vidrio y se le tumbo un espejo resultando así que en 24 horas más tarde, le sucedió a este vehículo lo mismo que al del Bronx.
LAS CONCLUSIONES DE ZIMBARDO es que las ventanas rotas, es decir, los daños visibles, envían un mensaje a la comunidad de permitir hacer daño, delinquir... no respetar. Si la ventana y el espejo se hubiesen reparado rápidamente el mensaje sería de que a ese objeto se le cuida, se le respeta y se le aprecia, por lo que no se hubiera vandalizado.
tar, fue un gobierno reactivo que improvisaba conforme los problemas iban surgiendo; por su parte la administración de Andrés Manuel López Obrador fue una gestión desde la ocurrencia, su proceso de construcción de acciones de gobierno se vivía en menos de dos horas, es decir era el Presidente lanzando una idea en la mañanera y en el transcurso del día se buscaba alinear todo para cumplir con el discurso dictado. HOY CLAUDIA SHEINBAUM TIENE que tener claro que no puede avanzar con un gobierno reactivo, uno que conforme da un paso y hasta eso momento piensa en cómo dar el siguiente; un gobierno que atiende la ocurrencia sin un rumbo fijo; que no es posible que los órganos del Estado se muestren desarticulados y caminando a destinos distintos; y que, si las cosas se hicieran bien, el ser reactivo sería la excepción en la toma de decisiones y no la regla.
HACE UNOS DÍAS VIMOS A UN Gobierno Federal anunciado “su lucha” contra los productos chinos en un operativo que resultó desastrosos en términos reales, por un lado, veíamos salir la mercancía y por otro entrando a los servidores públicos; 24 horas después el centro comercial abría sus puertas como si todo hubiera sido un sueño; y para cerrar con broche de oro, todo se vio como una medida desesperada por conseguir la simpatía de próximo presidente de Estados Unidos. LOS GOBIERNOS REACTIVOS tienden al fracaso y al despilfarro de recursos; ojalá la Titular de la Presidencia entienda que el gobernar si tiene ciencia, que hace falta, más que solamente el 10% de capacidad para ser servidor público; y que las decisiones del Estado no pueden ser improvisadas, sino producto de una planeación y de construcción mucho más amplia que la decisión unilateral del detentador del poder.
CUANDO APLIQUEMOS EL concepto de política pública, quizás las cosas cambien para el país y por supuesto ello necesariamente avanza por la ruta de reconocer que se logre brindar mejores servicios y productos a la ciudadanía para contribuir a su bienestar.

POR:
Todo movimiento en el mundo de lo tangible, antes fue interno. Porque antes de existir cualquier cosa creada por la humanidad, que pueda ser percibida con los sentidos físicos; fue una idea. Sabes cuándo un cúmulo de información, una energía, una creencia, o cualquier otra sustancia de lo intangible se mueve y transforma dentro de ti, porque ya no reaccionas o en el mejor de los casos, respondes igual ante los sucesos, las personas o la vida.
Cada partícula del agua al estar en Unicidad con el mar conforma un todo, pero también es verdad que a pesar de que siempre hay más y más flujo de torrente en el río, no se repite una sola gota. El río, nunca es el mismo río, a pesar de que nuestros ojos observan un mismo paisaje. Sabemos que todo está cambiando todo el tiempo. Afortunadamente. Porque si estamos estáticos, no crecemos. El beso no acaba de ser dado, la conexión no acaba de crear las chispas que conforman un nuevo amor, único e irrepetible. Sin movimiento no hay danza, sin la nota siguiente no hay sinfonía, sin la pérdida de la ignorancia no hay aplomo, respeto, creación y sabiduría.
Mover los bloques del inconsciente es sumamente necesario para seguir flotando hacia arriba, hacia las estrellas, hacia la luz. Estancarse es tener miedo y la rigidez solamente puede significar muerte, pero de esa muerte que no es transformación, sino que bloqueo.
¿Te ha pasado que muy en el fondo de tu corazón sabes que ya no quieres, no te conviene, no deberías o ya no te toca estar en el lugar al que estás tan apegado(a)?
Siempre es porque te está esperando una puerta más adecuada a tu nivel vibratorio, a tu Conciencia y a todo lo que has crecido. Pero te entiendo muy bien. Es que, nos da miedo.
Estamos programados en nuestro cerebro arcaico a quedarnos en lo familiar, así sea algo que nos lastima, porque su misión es hacer que el cuerpo sobreviva. Más no que viva. Más no que exista un disfrute, un gozo del Espíritu. Sin embargo, también es amoroso y si le vamos mostrando poco a poco que estaremos bien en ese nuevo sitio, incluso, nos ayudará.
Ese cerebro, es un guerrero, sin razón, sin corazón y sin conciencia espiritual. Pero
y ¿Qué pasa si usamos toda nuestra capacidad? Cuando nos encontramos frente a las puertas del cambio, habría que respirar tan profundo que cada inhalación y exhalación fungieran como hilos que unen la razón, el corazón, el instinto y el espíritu y confiar un poco más en esa intuición que es el susurro del Alma, que alcanza a ver mucho más que la mente pequeña del ego. La gente se hace esguinces, o cualquier otro síntoma que le impida seguir yendo a aquel lugar que ya no le está nutriendo, ni haciendo crecer. Si la vida terrenal, es un espejo de la programación del inconsciente y del Universo del alma, ¿Qué es lo que vamos a mirar frente a nuestros ojos? Seguramente si perdonamos, miraremos un mundo más compasivo. Si soltamos creencias de carencia y poco merecimiento, miraremos, tocaremos y saborearemos un mundo opulente y abundante en belleza y armonía. O bien, estaremos mucho más serenos frente a la adversidad. ¿Cómo fueron tus primeros cambios? ¿Todo cambió para ti con sufrimiento y dolor? Por favor, piensa en el primer cambio importante en tu vida. Te invito a reflexionar sobre ello y escribir un pequeño texto en dónde reconfigures el significado. Ante todo cambio hay que soltar algo y eso generalmente duele, pero no significa que siempre sea una pérdida trágica. Me gusta mucho una frase, si puedes y quieres, me encantaría que te la tatuaras como un mantra de luz: “Nada sale de tu vida, si no es para que llegue algo mejor.” Si regresas a tu corazón es sumamente seguro que prosperes allá a dónde vas, porque si tu mirada está lim-



...Estamos programados en nuestro cerebro arcaico a quedarnos en lo familiar, así sea algo que nos lastima, porque su misión es hacer que el cuerpo sobreviva. Más no que viva.
pia de prejuicio, culpa y rencor, podrás ver y escuchar los susurros de tu Alma. Porque es verdad que nunca estás solo(a). Siempre ha caminado contigo el Amor del que vienes. Cambiar es transformarse. No es lineal, es un espiral. Un inmenso espiral que no tiene otro camino que de vuelta al cielo, al hogar, a casa. No te negaré que los cambios internos duelen, porque nos desprendemos de lo viejo y lo conocido, pero cuando esto sucede, también es inevitable que cambiemos físicamente nuestra casa, lugar de trabajo, grupo social o costumbres, lo cual también duele, pero para eso es la tristeza, para ayudarnos a soltar y limpiar. Lo que sí, es que, amigándonos de estos procesos naturales, es que vamos a ser más felices, tendremos más paz y nos sentiremos más plenos. Bendice tus cambios. De todas formas, en esencia, fuiste, eres y serás El o La mismo(a). Pero mientras estemos aquí ¿Bailamos? Vivamos en este fractal de transformaciones y de escenas y más escenas. Que tus cambios sean siempre bendiciones. Que estés a salvo(a), que fluyas, que dances al ritmo que tu brillo Divino elija y te haga feliz.
Gracias por caminar juntos. Tu terapeuta. Claudia Guadalupe Martínez Jasso.

SanArte4
TERAPEUTA, COMUNICÓLOGA, CREADORA ESCÉNICA, AUTORA, ACTRIZ Y BAILARINA.
Conocimientos aplicados de: Biodescodificación, Recodificación integrativa, Gestalt, Constelaciones familiares, Metagenealogía, Sanación Cuántica Dimensional, Psicoterapia en danza y movimiento, Proyecto de Asención “Trece coronas”, Reiki, Psicoanálisis con inclinación Lacaniana, Nierika del campo punto cero, terapia humanista, comunicación telepática con animales no humanos, Yoga, Comunicación, Teatro, Danzas, Literatura, Teoría literaria, Dirección escénica, escritura creativa, Dramaturgia entre otros.








EGraciano
con el encendido del Árbol Monumental y la Decoración Navideña, un evento protagonizado por el Alcalde Juan Manuel Navarro Muñiz. En el marco de su lema “Soledad, Cerca de Ti”, el edil convocó a la sana convivencia y a disfrutar de esta especial celebración con esperanza y solidaridad.

Durante la celebración, el Alcalde Navarro Muñiz obsequió juguetes a todas las y los niños presentes, brindando momentos de felicidad; la Villa Navi deña y la decoración al interior de la Presidencia, fueron espacios para vivir momentos inolvidables y de unión familiar.

¡El mensaje de reflexión resaltó la importancia de solidaridad en esta época del año, recordando a los asistentes el verdadero espíritu navideño!


















En su presentación oficial como nuevo director técnico de las Chivas de Guadalajara, el estratega español Óscar García no escatimó en elogios hacia la grandeza del club. García destacó la relevancia global de Chivas, asegurando que en Europa es reconocido al mismo nivel que los gigantes Barcelona y Real Madrid.
"CHIVAS ES TAN GRANDE COMO BARCELONA O REAL MADRID"
El nuevo timonel del Rebaño Sagrado comenzó su intervención reflexionando sobre el impacto y la trascendencia que tiene Chivas en el mundo, especialmente en Europa. "Chivas en Europa es conocido como el Barcelona o el Real Madrid", expresó García, reconociendo la magnitud del club en el ámbito internacional. "Yo soy de Barcelona, pero la grandeza de este club es indiscutible. Cuando me llamó Juan Carlos (el presidente), me sentí el hombre más afortunado del mundo. Para mí venir a Chivas es como entrenar al Barça o al Madrid. En Madrid sé que nunca me llamarán, pero al Barça tal vez al día siguiente", añadió. Con una mezcla de entusiasmo y responsabilidad, García dejó claro que su llegada a Chivas es el resultado de una ambición de alto nivel. "Es una felicidad enorme, una responsabilidad, pero si no hubiera exigencia ni ambición no estaría aquí, por muy grande que sea el club. Y me convencieron muy rápido. Desde el primer día supe que quería venir", dijo.
Óscar García también dejó claro cuáles son sus expectativas para el equipo, con énfasis en el estilo de juego que desea implementar. "Mi idea de juego es ser protagonista, proactivo. Quiero que el rival reaccione a lo que propongo", expresó. Aunque reconoció que no es un "mago", destacó la importancia de trabajar desde el primer día en busca del campeonato. "No soy mago, pero vamos a trabajar desde la primera semana para conseguir lo que quiero. Me imagino un equipo apasionado, que sea un reflejo de la gente", puntualizó.
A pesar de los desafíos, García subrayó que no comparte la idea de que el fútbol mexicano esté en crisis. "No estoy de acuerdo con que el fútbol mexicano esté en crisis. Veo un nivel muy bueno, y no sé si haya en América una liga tan pareja como esta", señaló, transmitiendo optimismo sobre el nivel del fútbol en el país.
El técnico español también dedicó unas palabras de agradecimiento a la afición de Chivas, reafirmando su compromiso con el club. "Para mí es un honor que Chivas se haya fijado en mí. El fútbol da muchas vueltas, pero quiero estar el máximo tiempo posible. Quiero que la gente del Guadalajara se sienta orgullosa. Si conseguimos reflejar en el campo la dignidad, pasión y ambición que representan a este club, la afición estará orgullosa", concluyó.

STAFF
PLANO INFORMATIVO
La arquera Ana Paula Vázquez inició con fuerza en el Halcones Classic en San Luis Potosí, acumulando 269 puntos y posicionándose cuarta tras la primera jornada. Su precisión destacó con 9 tiros en el círculo de 10 puntos y 1 en el centro exacto del blanco. El liderato fue para Angela Ruiz, con 293 puntos. El torneo, que reúne a las mejores arqueras de México, continuará durante el fin de semana, donde Vázquez buscará escalar posiciones. Este evento es clave para el desarrollo del tiro con arco en el país, consolidando a Vázquez como referente del deporte.
STAFF
PLANO INFORMATIVO
Los Ángeles Galaxy y New York Red Bulls se enfrentan en la final de la MLS Cup. Los Galaxy, que bus can su sexto título, llegan tras anotar 16 goles en los playoffs, pero sin su estrella Riqui Puig, lesionado de gravedad. Ahora dependerán de Marco Reus, ex del Dortmund. Los Red Bulls, en busca de su primer trofeo, avan zaron sorprendiendo a rivales como Columbus Crew y Or lando City, liderados por Emil Forsberg. Este choque entre dos grandes ciudades depor tivas promete ser uno de los partidos más intensos del año. 2 - 1
STAFF
PLANO INFORMATIVO
El Atalanta venció al Milan 2-1, sumando su novena victoria consecutiva en Serie A, y se posiciona como líder temporal en Italia. Este resultado refuerza su impresionante racha de 13 partidos invictos en todas las competiciones. El equipo de Bérgamo, con un nivel sobresaliente, enfrentará al Real Madrid en la Liga de Campeones, buscando venganza tras su derrota en la Supercopa de Europa. Contra el Milan, Charles De Ketelaere marcó temprano, y aunque Álvaro Morata empató, un gol decisivo de Lookman en el 87’ aseguró la victoria. Atalanta es candidato al título en Italia y amenaza en Europa.


Leclerc sancionado con pérdida de 10 puestos en parrilla
AGENCIAS
Charles Leclerc, piloto de Ferrari, perderá 10 posiciones en la parrilla del Gran Premio de Abu Dabi tras cambiar la batería de su SF-24. Actualmente, lucha por la segunda posición del campeonato contra Lando Norris, con ocho puntos de diferencia. En el Mundial de Constructores, McLaren lidera con 21 puntos sobre Ferrari, lo que añade presión para este último evento de la temporada. El neerlandés Max Verstappen ya aseguró el título, pero las disputas restantes prometen un cierre emocionante.
Messi, tras recibir el MVP: “El esfuerzo tiene su recompensa”
STAFF
PLANO INFORMATIVO
Lionel Messi, estrella del Inter Miami, recibió el MVP de la MLS tras registrar 20 goles y 16 asistencias en su primera temporada. Durante la ceremonia, donde fue sorprendido por su familia y jóvenes de la academia del club, expresó su felicidad viviendo en Miami y alentó a los jugadores a perseguir sus sueños. Aunque lamentó no haber llegado a la final de la MLS, Messi prometió volver con más fuerza en 2024. El argentino destacó la evolución del club y su compromiso con el crecimiento de la academia como base para el futuro.



Va a tener que pagar lo que debe: dice CSP a Salinas Pliego
AGENCIA REFORMA
La Presidenta Claudia Sheinbaum afirmó que el empresario Ricardo Salinas Pliego deberá pagar los impuestos que debe.
Cuestionada sobre críticas del dueño de Grupo Salinas, la Mandataria aseguró que la justicia se puede tardar pero “siempre llega”.
“Bajaron un montón las acciones de Elektra”, dijo Sheinbaum a la pregunta sobre las críticas del empresario.
-¿Qué les diría a quienes como él intentan deslegitimar su mandato con estos discursos?, se le preguntó.
“Como cualquier ciudadano mexicano, mexicana, pues tiene que pagar sus impuestos”.
“Entonces no voy a traer ese debate la verdad, pero fíjense no le está ayudando, la verdad, vean las acciones cómo cayeron”.

AGENCIA REFORMA
Enrique de la Madrid anunció el fin de su ciclo en el PRI para buscar otros espacios en los que se sume en la construcción de diálogos positivos.
“Después de una amplia reflexión, llegué a la conclusión que mi ciclo en el PRI ha terminado. Creo que un Mucho Mejor México Es Posible, un México próspero, justo, seguro, sustentable y en paz donde todos quepamos y donde todos tengamos oportunidades para ser quienes queramos ser y contribuir a la Grandeza Mexicana”, posteó en redes sociales.

Te invitamos a leer nuestra versión web.

La Presidenta Claudia Sheinbaum in-
formó que la Comisión Federal para la Protección contra Riesgos Sanitarios (Cofepris) suspendió a la empresa SAFE, tras la muerte de 13 menores de edad, relacionada con el brote de la bacteria Klebsiella oxytoca en hospitales públicos y una clínica privada del Estado de México.
La Mandataria dio a conocer que el contrato con la compañía Productos Hospitalarios SA de CV, también fue suspendido, luego de detectarse una conexión entre el uso de soluciones intravenosas de nutrición parenteral preparadas, con el fallecimiento de los niños.
“Se suspendió de inmediato el contrato, se pidió que se suspendiera el contrato y el registro que tenían de este alimento que se da a los pequeñitos, a los bebés, la mayoría son prematuros, nacieron antes de las 40 semanas”, dijo.
El contrato con la compañía Productos Hospitalarios SA de CV fue suspendido, luego de detectarse una conexión entre el uso de soluciones intravenosas de nutrición parenteral preparadas, con el fallecimiento de los niños.
“Cofepris suspendió por lo pronto a la empresa, se está haciendo los estudios de cultivos para saber cuál es la causa y está personalmente el secretario de Salud investigando”.
Tras lamentar los hechos, en conferencia, Sheinbaum informó que, por sus instrucciones, el caso es atendido personalmente por el Secretario de Salud, David Kershenobich.
“Está desde el primer momento el Secretario de Salud, es muy triste que haya ocurrido esto. El objetivo primero es atender a las familias y se está investigando la causa de estos fallecimientos que se dieron no solo en un hospital sino en varios, por una bacteria”, agregó.
La Secretaría de Salud informó que el brote se registró desde noviembre pasado, en tres hospitales públicos y una clínica pri-
México no se subordinará a EU: Sheinbaum
EFE
En respuesta a las nuevas declaraciones del presidente electo de EU, sobre la conversación telefónica que sostuvieron, la Presidenta Claudia Sheinbaum ratificó que con México habrá colaboración sin subordinación.
La mandataria rechazó que en esa plática ella hubiera reprochado el amago de la imposición de aranceles.
“Trump tiene una manera de comunicar, fue como cuando tuvimos la llamada y él hace una publicación donde dice que vamos a cerrar la frontera, y nunca se habló de eso, tampoco (de los aranceles), lo que les planteé aquí así fue la llamada», aseguró Sheinbaum.

vada, en pacientes pediátricos, que van desde los 0 hasta los 14 años.
De 20 casos detectados, se registraron 13 defunciones de pacientes que poseían comorbilidades, por lo que se encuentran en proceso de dictaminación para determinar si la causa de muerte está asociada a la ITS por Klebsiella oxytoca MDR.
Por otro lado, se reportaban siete pacientes hospitalizados, que reciben atención en el Estado de México. El 3 de diciembre, el Gobierno federal emitió una alerta epidemiológica por los contagios en esa entidad, los cuales son por infección del torrente sanguíneo, relacionado a posible contaminación de nutrición parenteral o insumos relacionados con su aplicación.
Sheinbaum, entre las 25 mujeres más influyentes del 2024: Financial Times
La presidenta Claudia Sheinbaum Pardo apareció en el listado de las ‘25 mujeres más influyentes de 2024‘, revelada este viernes por el diario británico Financial Times
En la semblanza, se detalló que Sheinbaum Pardo hizo historia al convertirse en la primera presidenta de México, además de que también reconoció sus estudios científicos y su carácter “férreo”.
tres meses en ascenso y alcanzan los 45 mil 500 afianzar a México como primer proveedor y socio
mexicanas hacia máximo consolidánclave en la bilateral. registraron millones meses de ininterrumpido, según Censo estaoctubre enviado en 3 por septiembre
Valdelamar / PÁG. 4
Delgado
SOBREAVISO / 32

AGENCIA REFORMA
Leopoldo Gómez DESDE EL OTRO LADO / 36
Alejandro Moreno LAS ENCUESTAS / 45
Edel INE de Moelectoorganización popular de ministros 205 mi-
llones de pesos que pidieron para este proceso “no es un presupuesto caprichoso”, sino “el costo de la legitimidad”. En ausencia de Guadalupe Taddei, la consejera Rita López dijo que ese monto es lo mínimo que se requiere. —Víctor Chávez / PÁG. 40

'MATARON' LA
n una reunión de casi tres horas, integrantes del Consejo Mexicano de Negocios expresaron sus preocupaciones a la presidenta Claudia Sheinbaum sobre diversos temas, entre los que destacaron la inseguridad, el cobro de piso por parte del crimen organizado, las deportaciones masivas de migrantes, los retos económicos y la continuidad del T-MEC. Empresarios de Sinaloa, como Agustín Coppel y Claudio X. González Laporte, manifestaron su preocupación por la violencia y el impacto de los derechos de piso, los cuales consideran un “impuesto” ilegal. A pesar de que Sheinbaum aseguró que se está actuando para erradicar estas prácticas, reconoció que tomará tiempo. Además, empresarios de Coparmex Sinaloa pidieron la condonación de impuestos y cuotas obrero patronales, debido a las pérdidas económicas causadas por la violencia en la región, que ha provocado la pérdida de 25 mil empleos. La presidenta de Coparmex Sinaloa, Martha Reyes Zazueta, también solicitó que se amplíe el programa “Jóvenes Construyendo el Futuro” para incluir a personas de mayor edad y reiteró la urgencia de medidas emergentes para los municipios afectados por el crimen organizado.
PÁG. 41
Durante la reunión, los empresarios destacaron que la violencia en Sinaloa ha provocado pérdidas de hasta 18 mil millones de pesos
Por su parte, el subsecretario de Economía, Vidal Llerenas, se comprometió a realizar mesas de trabajo y a facilitar contacto con la Secretaría de Hacienda.
AGENCIA REFORMA
De enero a noviembre, el IMSS registró 619,252 plazas laborales, una disminución del 40.2 por ciento en comparación con el mismo periodo de 2023. Este descenso está por debajo del pro-
medio de los últimos tres años, que fue de un millón de empleos anuales.
Aunque el empleo formal creció un 1 por ciento a nivel nacional, alcanzando 22.6 millones de puestos, la tasa de crecimiento fue
la más baja en 43 meses. En noviembre, solo se crearon 24,696 plazas, la menor cifra en 16 años. Por sectores, transporte y comunicaciones fueron los que más crecieron, mientras que Tabasco reportó la mayor caída.
La industria automotriz en México perdió aceleración en los primeros once meses de 2024, con un crecimiento del 5.65 por ciento en la producción de vehículos ligeros, una desaceleración de 10.46 puntos respecto al año anterior. A pesar de ello, la producción alcanzó un récord de 3.76 millones de unidades, y las exportaciones también lograron su cifra más alta con 3.21 millones de vehículos.
Las ventas internas aumentaron un 10.68 por ciento, siendo el volumen más alto en siete años. En noviembre, la producción subió un 6.74 por ciento y las exportaciones crecieron un 2.85 por ciento.

AGENCIA REFORMA
Las empresas de gas LP en México han solicitado un aumento del margen comercial hasta 7.50 pesos por kilogramo, argumentando que este incremento es necesario para cubrir costos operativos y mantener la infraestructura. Actualmente, el margen es de 3.98 pesos. La propuesta, que ha sido discutida con la Comisión Reguladora de Energía (CRE), busca destinar parte de ese aumento a inversiones en seguridad. Aunque los precios internacionales han subido, el precio máximo al público se ha mantenido constante, lo que genera dificultades operativas.


Guerrero fue la entidad con mayor aumento en empleos formales, con un crecimiento del 5.9 %
Los misiles Oréshnik son indetectables para los sistemas de defensa antimisiles occidentales
EFE
El presidente ruso, Vladímir Putin, anunció el despliegue de misiles balísticos hipersónicos Oréshnik en Bielorrusia, como parte de las medidas de seguridad ante la OTAN. Durante su visita a Minsk, Putin detalló que los misiles estarán operativos en 2025 y apuntarán a objetivos en Europa, aunque las decisiones las tomará Bielorrusia. Estos misiles, de alta precisión y sin componentes nucleares, pueden alcanzar capitales europeas rápidamente. Además, ambos países firmaron un acuerdo de seguridad y defensa mutuo, incluido el uso de armas nucleares tácticas si es necesario.


AGENCIA REFORMA
Un tribunal federal de apelaciones de EU ratificó la ley que obliga a ByteDance, la empresa matriz de TikTok, a vender la aplicación o enfrentar su prohibición en el país. La Corte rechazó el argumento de TikTok de que la medida es inconstitucional y viola la Primera Enmienda. Si ByteDance no vende TikTok antes del 19 de enero, las tiendas de aplicaciones y proveedores de Internet deberán eliminarla. La medida responde a preocupaciones sobre la seguridad nacional y los vínculos de TikTok con el gobierno chino.
La República Democrática del Congo (RDC) enfrenta una crisis sanitaria en la provincia de Kwango, donde una enfermedad misteriosa ha dejado al menos 71 muertos y 382 casos detectados.
El ministro de Salud, Samuel Roger Kamba Mulamba, informó que los síntomas incluyen fiebre, tos, dificultad para respirar, dolor de cabeza, y anemia. Aunque se sospecha que la enfermedad es respiratoria, no se ha confirmado si es viral o bacteriana.
A pesar de los esfuerzos para obtener resultados de laboratorio, la falta de infraestructura en la zona remota de Panzi ha complicado la investigación.
La tasa de mortalidad de la enfermedad ronda el 7.5 por ciento, lo que descarta el COVID-19, aunque los expertos investigan si factores como la malnutrición y enfermedades como el sarampión y la malaria podrían haber incrementado la letalidad.
El 24 de octubre se registraron los primeros casos, pero la alerta no se activó

hasta finales de noviembre, cuando un equipo de epidemiólogos viajó a la zona. La situación se complica debido a que el sistema de salud local no cuenta con los recursos necesarios, como oxígeno, para enfrentar este brote.
Mientras tanto, la Organización Mundial de la Salud (OMS) y los Centros para el Control y Prevención de Enfermedades de África están colaborando con las autoridades congoleñas para investigar la causa de la enfermedad y fortalecer las medidas de respuesta.


El presidente electo de EU, Donald Trump, realizará su primer viaje internacional tras su victoria electoral al participar en la reapertura de la catedral de Notre Dame en París. Invitado por el presidente francés, Emmanuel Macron, Trump estará acompañado de líderes internacionales, como la presidenta de la Comisión Europea, Ursula von der Leyen, y el presidente italiano, Sergio Mattarella. El evento marca su regreso a la escena global, destacando sus propuestas de política exterior, que incluyen acabar con la guerra en Ucrania y revisar el T-MEC con México y Canadá.

Escanea el QR Te invitamos a leer nuestra versión web.


La República del Congo continúa luchando contra una epidemia de mpox, con más de 47,000 casos sospechosos y más de 1,000 muertes


AGENCIA REFORMA
El presidente electo de Estados Unidos, Donald Trump, reveló que la presidenta de México, Claudia Sheinbaum, le recriminó su amenaza de imponer un arancel del 25 por ciento a las importaciones mexicanas si no detenía la migración irregular.
Durante una cena en Nueva York, Trump relató que Sheinbaum le respondió que no entendía su medida, a lo que él respondió que era necesaria para frenar el ingreso de criminales. Aunque ambos coinciden en el compromiso mexicano de abordar el problema migratorio, las versiones sobre su conversación difieren en detalles.
4.5 millones de migrantes venezolanos, regularizados en Latinoamérica

EFE
Más de 4,5 millones de migrantes y refugiados venezolanos han regularizado su estatus en América Latina y el Caribe desde 2019, con 1,3 millones de ellos en 2024, gracias a esfuerzos de los gobiernos y apoyo internacional.
La Plataforma R4V presentó un plan de respuesta para 2025-2026 que requiere 1.400 millones de dólares para apoyar a más de 2,3 millones de personas vulnerables. Aunque se ha logrado progreso en la integración, persisten desafíos económicos, políticos y sociales que dificultan la estabilidad y el acceso a servicios básicos.
EFE
El presidente surcoreano, Yoon Sukyeol, enfrenta una posible destitución tras perder el apoyo de su partido, el Partido del Poder Popular (PPP), debido a la reciente orden de imponer la ley marcial. Su jefe de partido, Han Dong-hoon, instó a suspenderlo, citando pruebas de acciones radicales que ponen en peligro al país.
A pesar de las tensiones internas y rumores sobre una nueva ley marcial, el ministro de Defensa interino negó estos rumores. La moción de destitución requiere dos tercios del Parlamento, lo que podría llevar a la caída de Yoon.
Nueva Delhi vuelve a la ‘normalidad’ tras meses asfixiantes
La calidad del aire en Nueva Delhi mejoró a la categoría "moderada", después de dos meses de alta contaminación. Según el Sistema de Calidad del Aire (SAFAR), el Índice de Calidad del Aire (ICA) promedio fue de 138, lo que permitió la reanudación de las clases presenciales en las escuelas de la ciudad. Esta mejora sigue a las restricciones que suspendieron actividades como la enseñanza presencial y la industria. No obstante, se prevé un nuevo deterioro del aire para el domingo, con un aumento del ICA a 300.


AGENCIA
Lupillo Rivera, el cantante de música regional mexicana, informó que los tres conciertos que tenía programados para este fin de semana no se podrán llevar a cabo, debido a que fue internado en el hospital.
Esta noticia llega luego de que el intérprete canceló el concierto que daría el martes 3 de diciembre en Bochil, Chiapas.
Según con el reporte, el cantante ha tenido complicaciones de salud desde hace días: “Lupillo Rivera ha presentado síntomas de dolor estomacal ocasionados por una bacteria”, señalaron, por lo que el cantante fue llevado al hospital.
Se desconoce con precisión el diagnóstico de Lupillo Rivera; sin embargo, MedlinePlus explica que entre los síntomas comunes de una gastroenteritis bacteriana, es decir una infección bacteriana del estómago, se encuentran cólicos, dolor abdominal, pérdida de apetito, náuseas, fiebre y vómitos.
AGENCIA REFORMA
Paris Jackson, hija de el Rey del Pop, Michael Jackson, anunció que está comprometida con su compañero de banda Justin Long, modelando en redes sociales su deslumbrante anillo.
La modelo, de 26 años, reveló que se casará con el productor de 5 Seconds of Summer en una publicación de Instagram, incluyendo una foto de la propuesta y un montaje de su tiempo juntos.
"Feliz cumpleaños mi dulce azul. Vivir la vida contigo estos últimos años ha sido un torbellino indescriptible y no podría soñar con alguien más perfecto con quien hacerlo todo. Gracias por dejarme ser tuya. Te amo", escribió Paris en la publicación.
Si bien no se especificó el lugar y la fecha de la propuesta, se vio a Paris usando el anillo en septiembre.



En pleno comienzo de la temporada de premios, el American Film Institute (AFI), en español Instituto Estadounidense del Cine, ha anunciado los 20 proyectos de cine y televisión ganadores de este 2024.
Estos galardones reconocen las 10 mejores películas y las 10 mejores series del año, indistintamente del género, y condecoran en su conjunto a los equipos creativos de cada producción y a quienes están delante y detrás de la cámara. Resulta, además, que normalmente varias de las mencionadas por el AFI acaban logrando la nominación al Oscar.
No sorprende para nada la elección de la secuela de Dune dirigida de nuevo por Denis Villeneuve y protagonizada por Timotheé Chalamet, que también
AGENCIA REFORMA
La adaptación televisiva de Como Agua para Chocolate fue renovada para una segunda temporada en Max, reveló la productora ejecutiva Salma Hayek.
Hayek, quien participó en la presentación del servicio de streaming en Londres, aseguró que esta sería la última entrega de la serie.
"No queremos hacer más de dos temporadas. Queremos hacer algo realmente especial y asegurarnos de no diluirlo al tratar de alargar la historia", explicó la mexicana, de 58 años.
es el actor protagonista de A complete unknown, el biopic sobre Bob Dylan que dirige James Mangold y que la AFI considera como otro de los títulos imprescindibles del año.
Emilia Pérez, el narco musical queer de Jacques Audiard rodado en español también está en la lista. Igual que Anora, la película de Sean Baker que ganó la Palma de Oro en el festival de Cannes y que apunta a sumar varios galardones.
El drama histórico épico protagonizado por Adrian Brody, The brutalist, escrito y dirigido por Brady Corbet, tuvo una buena acogida en el festival de Venecia, logrando el premio al mejor director. Se trata de una producción de A24, que suma en la lista de lo mejor del año a Las vidas de Sing Sing, una película de Greg Kwedar sobre un pequeño grupo de presos encarcelados
en un centro correccional de máxima seguridad que se propone montar su propia obra teatral como parte de un taller de teatro.
Completan la lista del top 10 Conclave, el thriller religioso del alemán Edward Berger con un excepcional Ralph Fiennes; Nickel Boys, otro de los filmes que suenan fuerte en la temporada de premios y que narra la poderosa amistad entre dos jóvenes afroamericanos que atraviesan juntos las duras pruebas del reformatorio de Florida; A Real Pain, el drama sobre el Holocausto dirigido e interpretado por Jesse Eisenberg y Wicked, ambientada en la Tierra de Oz con Ariana Grande y Cynthia Erivo. La adaptación de uno de los musicales más populares y longevos de Broadway se ha coronado como uno de los eventos cinematográficos del año.

Basada en la icónica novela de Laura Esquivel publicada en 1989, la serie narra la historia de Tita y Pedro, dos amantes que luchan contra las rígidas tradiciones familiares que les impiden vivir su amor. Tita encuentra consuelo en la cocina, donde la magia y los sabores se
convierten en su refugio mientras busca su propio destino y libertad. La serie se estrenó el 3 de noviembre en Max y ha sido protagonizada por Azul



PELÍCULAS
• Anora
• The Brutalist
• A Complete Unknown
• Conclave
• Dune: Part Two
• Emilia Pérez
• Nickel Boys
• A Real Pain
• Las vidas de Sing Sing
• Wicked
SERIES DE TELEVISIÓN
• Abbott Elementary
• The Bear
• Hacks
• Un hombre infiltrado
• Mr. and Mrs. Smith
• Nadie quiere esto
• The Penguin
• Shōgun
• Shrinking
• True Detective: Noche polar
AGENCIA REFORMA
La serie de Harry Potter comenzará a filmarse el verano de 2025 en los estudios Leavesden, donde se filmaron las ocho películas originales.
La noticia fue revelada por la showrunner Francesca Gardiner y el productor ejecutivo Mark Mylod durante su aparición en el Max Showcase en Londres, junto al jefe de HBO, Casey Bloys.
Según Gardiner, la serie tendrá una producción "muy, muy específicamente
Bloys, se reflejará en cada aspecto del proyecto.
Una de las revelaciones más emocionantes fue el impresionante número de actores que se postularon para los papeles principales de Harry, Hermione y Ron. En total, 32 mil jóvenes audicionaron para estos roles, lo que subraya la magnitud de la expectativa que genera este proyecto, según informó Deadline.
La showrunner también adelantó que, en cuanto a los demás personajes, se adherirán a las edades "canónicas" de los libros.
Esto implica que personajes como Severus Snape, quien según rumores podría ser interpretado por Paapa Essiedu, solo tendrá 31 años, lo que difiere de la interpretación de Alan Rickman en las




Max Verstappen, piloto de Red Bull y tetracampeón de Fórmula 1, anunció que será papá por primera vez junto a su pareja Kelly Piquet, hija del triple campeón mundial brasileño Nelson Piquet.
Por medio de su cuenta de Instagram, Verstappen y Piquet dieron a conocer la noticia que causó reacciones.
"¡Mini Verstappen-Piquet en camino! No podríamos estar más felices con nuestro pequeño milagro", se lee en el breve mensaje que Kelly y Max publicaron en sus redes sociales.

AGENCIA REFORMA
A 27 años de su inicio, el Teletón tiene como meta recaudar 415 millones 119 mil 436 pesos, más un peso, para ayudar a personas con discapacidad. Además esta edición promete el regreso de Lucero a la conducción y nuevos números musicales.
Fernando Landeros, presidente de Fundación Teletón, destacó la sensibilidad de la presidenta Claudia Sheinbaum Pardo, ya que anunció que el próximo año el gobierno federal destinará 900 millones de pesos para la rehabilitación de personas con discapacidad.
La parte musical estará a cargo de Mijares, Lucero Mijares, Erik Rubí y su hija Mía, María León, Yahir, María José, Jesse & Joy, Flans, Picus y Los Meñiques de la Casa.
Andrea Escalona, Tania Rincón, Negro Araiza, Arath de la Torre, Paul Stanley y Nicola Porcella serán algunos de los conductores que amenizarán el evento que se realizará en el Foro Teletón a las 8:00 horas con la presentación del himno "Te Doy Todo" interpretado por Lucero Mijares, Aleks Syntek, Benny Ibarra y Alexander Acha.

VILLA DE POZOS, S.L.P.,.- Dos menores, de 6 y 7 años respectivamente, murieron intoxicados y sus padres fueron encontrados inconscientes dentro de su vivienda, ubicada en la colonia Silos, perteneciente a este municipio, aunque se ignora aún qué fue lo que causó esta tragedia. De acuerdo con información extraoficial, la tragedia fue descubierta por una persona que
llegó al taller de maderería en cuyo interior hay cuartos que presuntamente se alquilan a los trabajadores foráneos, lugar donde encontró el dramático cuadro.
Los reportes iniciales detallan que los padres de las víctimas, que están siendo atendidos en un hospital de la capital, son originarios del estado de Michoacán y presuntamente se encontraban en San Luis Potosí trabajando.
Como primeros respondientes se presentaron agentes de
la Guardia Civil del Estado, que aseguraron el lugar y posteriormente llegaron elementos de la Policía de Investigación y Peritos de la Fiscalía General del Estado, que luego de recopilar las evidencias de la escena de esta tragedia, en la que perdieron la vida un niño y una niña, procedieron a levantar los cuerpos de los menores para trasladarlos a las instalaciones del Servicio Médico Legal, en donde se determinará la verdadera causa de sus muertes.

STAFF
PLANO INFORMATIVO
VILLA JUÁREZ, SLP.Movilización se registró en la localidad de Puerta del Río, cuando fue reportada al interior de su domicilio una mujer sin vida a donde acudieron distintas corporaciones.
La mujer fue identificada como María Dora de 58 años de edad, quién fue localizada al interior de su domicilio, cuando lamentablemente ya no se pudo hacer nada por salvarle la vida.
Trasciende que la mujer ya había manifestado en distintas
Derivado de las acciones de seguridad, efectuadas en los Puestos de Atención
Ciudadana, agentes de la Guardia Civil Estatal (GCE) aseguraron 600 kilos de paxtle o heno, de probable procedencia ilegal.
Las autoridades preventivas detectaron al tripulante de una camioneta marca Ford, línea Ranger, la cual estaba cargada con gran cantidad de heno, por ello se le indicó al conductor de la unidad que se detuviera. Al cuestionarle sobre
Aseguran inmueble con unidades de carga de procedencia ilícita
Operativos de inteligencia desarrollados por la División Caminos de la Guardia Civil Estatal (GCE), permitieron la ubicación y aseguramiento de un inmueble en donde podría haber unidades de carga de procedencia ilícita. Los hechos tuvieron lugar
CIUDAD FERNÁNDEZ, SLP.Elementos de Seguridad
la procedencia legal del recurso natural, no pudo comprobar el origen, por ello se le hizo de conocimiento que se le decomisaría dicho material, siendo 600 kilogramos, por ello se procedió a poner a disposición de la PROFEPA lo asegurado. Cabe señalar que, en el territorio mexicano, la venta y compra de musgo y heno es ilegal, con base a los tratados de la Ley General de Equilibrio Ecológico y Protección del Medio Ambiente, por ello, si una persona es captada en posesión de un recurso natural sin que tenga un permiso especial o programa para su manejo adecuado, las autoridades competentes tienen la capacidad del aseguramiento del recurso natural y, en los casos que sea debido, la detención del o las personas.
en la colonia Los Salazares, efectivos de la División Caminos visualizaron en la zona un tractocamión, acoplado a una caja seca, ambas en aparente abandono y abiertas, por ello se desplegaron por la zona, a fin de detectar algún tripulante. Metros adelante ubicaron un inmueble en donde salió un vehículo de carga y otro más doblemente articulada, misma que había sido asegurada previamente por los agentes de la GCE. Ante ello, procedieron a dar aviso de inmediato a la Fiscalía General de la República, para las averiguaciones correspondientes.
donde los elementos custodian al pequeño.
ocasiones sus intenciones de quitarse la vida, siendo la tarde de ayer cuando fue localizada. Se hace un llamado a la población para que en caso de detectar situaciones de riesgo en cuanto a depresión acudir a las instancias que brindan apoyo psicológico de manera gratuita.
Pública Municipal de Ciudad Fernández desplegaron un operativo en el ejido El Refugio, donde un menor de 4 años fue abandonado en un súper.
La noche del jueves elementos de Seguridad Pública Municipal de Ciudad Fernández, atendieron el llamado de emergencia en el Barrio Segunda de El Refugio,
Los elementos arribaron a un Minisuper 2015 que está ubicado en la calle Emiliano Zapata donde un menor fue localizado en la tienda donde ya llevaba más de dos horas que su papá lo había dejado en el lugar.
Aparentemente el padre del menor enfrenta adicciones y se dedica a cantar en los establecimientos de venta de alimentos, siendo común que deje al niño en la tienda durante un breve periodo, sin embargo esta vez se prolongó la espera.

ANALISTA Y ECONOMISTA
ADRIÁN TOVAR
PLANO INFORMATIVO
El analista y economista Gustavo Puente Estrada, señaló que “El bienestar social viene de que la gente tenga empleo y que el empleo les dé seguridad social, les dé vivienda, les dé salud, les dé educación a sus hijos”.
Ese es el bienestar social verdadero. Nos conviene Estados Unidos definitivamente.
Es muy importante, como serenamente lo comentó el segundo día la presidenta de México, la doctora Scheinman, hay que negociarlo, hay que verlo, porque alguien le decía si nos dan 25% de arancel nosotros también vamos a cobrarle.
No, no podemos hacerlo con el país económicamente más poderoso del mundo. Tenemos que ser serenos y estas decisiones no son viscerales, tiene que ser la mente.
También Donald Trump habló mucho en sus campañas sobre la droga del fentanilo, que está entrando a Estados Unidos.
COMERCIO CON CHINA
PONE MUY DE MALAS A EU Y algo muy sensible, muy especial, es el comercio que tenemos ahora con China, la industrialización, sobre todo en el área automotriz, de inversiones chinas en México. Para diciembre de este año 2024, posiblemente ya tengamos 25 marcas en distribuidoras o en armadoras de vehículos chinos. Y eso a Estados Unidos lo pone

muy de malas, porque Donald Trump lo entendió muy claro.
Dice ‘los chinos están asentándose en tierra de México para poder triangular y entrar al mercado del T-MEC’.
Hay que recordar que la economía de México creció ya en forma industrializada en la Segunda Guerra Mundial, cuando Estados Unidos nos pide que le maquilemos muchos productos, porque él estaba ya en guerra.
Y el despegue, ya el último despegue, es a partir de enero de 1994, cuando da inicio el Tratado Libre Comercio.
Y eso nos origina y nos obliga a que nosotros tengamos una industria ya muy moderna y también a que la educación a jóvenes y mayores sea de técnica y tecnológica. Eso nos ha beneficiado mucho.
Algo muy importante que está sucediendo a la economía de México y a la política, es que desde la campaña política del presidente electo de Estados Unidos, Donald Trump, que toma posesión el próximo 20 de enero del 2025, fue dirigida mucho a México, hablando sobre la migración que viene desde Centroamérica, muchos mexicanos también, que está entrando ilegalmente a Estados Unidos.
Sin embargo, a Estados Unidos, en el T-MEC, le vendemos el 84% de todo lo que exportamos.
Nos compra todo y nos paga todo. El año pasado, 2023, nuestro comercio binacional fue de 800 mil millones de dólares. En números redondos le vendimos 400 y nos vendió 400.
Algo muy importante, somos el tratado de comercio más importante del mundo, Canadá, Estados Unidos y México.
Alguien de la Secretaría de Comercio a nivel federal comentó que Estados Unidos se estaba dando un balazo en el pie. No es verdad. Se mencionó que podría perder 400 mil empleos si Estados Unidos nos pone el arancel, el impuesto del 25% a todos los productos que vendamos a la Unión Americana, en caso que no limitemos o detengamos la venta de fentanilo y los migrantes.
Pero la verdad es que si Estados Unidos pierde 400 mil empleos, México perderá como 5 millones de empleos formales. Hay que recordar que en la pura franja fronteriza México-Estados Unidos hay 2 millones y medio de empleos formales. Ahí esas maquiladoras producen pantallas de televisión, celulares, computadoras.
Ese es el comercio internacional que tenemos. Somos la envidia de muchos países y no vamos a perderlo más, por lo menos.
así lo dijo
Somos el tratado de comercio más importante del mundo, Canadá, Estados Unidos y México
CASI 100 MMDD, LA PEQUEÑA DIFERENCIA
Sin embargo, con China, pues el año pasado nos vendió 114 mil millones de dólares y nosotros le vendimos 18 mil millones de dólares. Esa es la diferencia.
China nos utiliza y puede entrar al mercado de Norteamérica. China nos compra acero, no le interesa comprarnos más. Y nosotros le compramos autopartes, le compramos muchos más productos, todos terminados.
Nos pasa igual que a Brasil. China le compra artículos de materia prima y se los vende ya procesados. ¿Cuál es la conveniencia de México?
La conveniencia de México es que tengamos que ir con quien tenemos seguro el mercado, con quien tenemos muchos años, pero muchos años sin ningún problema y el 80-84% de nuestro comercio internacional está ahí, en el T-MEC.
